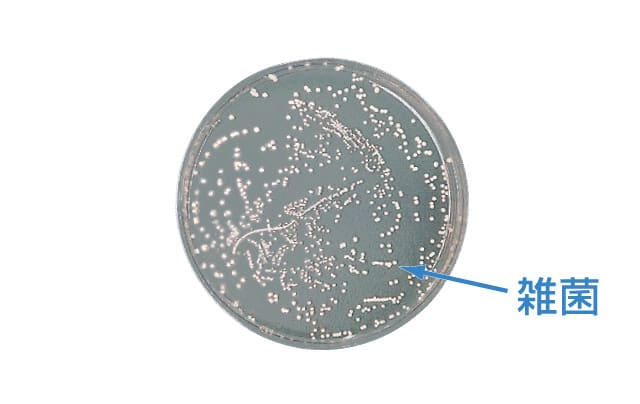
LES | シャンソン化粧品

シャンソンLesクレンジング他 シャンソン化粧品 / LES クレンジングクリームの商品情報|美容
(2960件)
Pontaパス特典
サンキュー配送
7598円(税込)
76ポイント(1%)
Pontaパス会員ならさらに+1%ポイント還元!
送料
(
)
2942
配送情報
お届け予定日:2026.05.02 6:18までにお届け
※一部地域・離島につきましては、表示のお届け予定日期間内にお届けできない場合があります。
ロットナンバー
7443341898
お買い物の前にチェック!

Pontaパス会員なら
ポイント+1%
ポイント+1%
商品説明

セルキスフォームLesクレンジング2本UVクリーム
| カテゴリー: | コスメ・美容>>>スキンケア・基礎化粧品>>>洗顔料 |
|---|---|
| 商品の状態: | 新品、未使用","新品で購入し、一度も使用していない |
| 配送料の負担: | 送料込み(出品者負担) |
| 配送の方法: | 佐川急便/日本郵便 |
| 発送元の地域: | 未定 |
| 発送までの日数: | 1~2日で発送 |
レビュー
商品の評価:




 4.8点(2960件)
4.8点(2960件)
- sake568
- よくもなく悪くもなくといったところでしょうか?普段から使う洗顔フォームですのでコストパフォーマンスのよい商品がいいですね。
- りん1019
- 毎日利用しています。アレルギーテスト済みなので安心して利用しています。 250457-20120603-0869992208
- 生生茶
- 価格の安さにお試しで購入してみました。リピで購入できれば良いのですが・・・!
- momomama72
- 嫁に頼まれて購入しました。 市販の3割引かつポイントがつくということで妻も私も大満足です。 化粧品なんて、電化製品と同じでものはどこで購入しても変わらないのだから、安ければ安いほどいいに決まってます。 リピします。
- さーふ11
- とても泡立ちがよく、洗い終わった後スースーするので今の季節には持ってこいだと思います。
- トム王子。
- 可もなく、不可もなくといった印象です。 ただウォーターローションの使用感は抜群なので、ついついセットで買ってしまいます。
- X-PlMi
- この洗顔フォームは初めて使います。 優しい香りで、泡立ちも良く(泡立てネットを使ってますが)、 洗顔後もつっぱることなく、気に入っています。
- 55にゃんとも
- 既に一か月経ちましたが、一度もサポート電話はありませんでした。 DVDとプロティンはよかったです。 特にプロティンは、おいしかったです。
- なおっち0512
- 使用して4日目、、何も変わらない!!なんでだろう? はぁーー!!がっかり! 5日目、ボロボロとむけた! でも、ツルツルにはならなかった! ガチガチかかとには、一回では無理だった!
- ともりんご5780
- 最近はこればかり使用しています。使い勝手がよいです。
- あ71237744
- まだ使用していませんので何ともわからないですが。。。 DHCなので気になって購入しました。期待してます。
- tomo85790448
- 価格の安さにお試しで購入してみました。リピで購入できれば良いのですが・・・!
- SOR
- 嫁に頼まれて購入しました。 市販の3割引かつポイントがつくということで妻も私も大満足です。 化粧品なんて、電化製品と同じでものはどこで購入しても変わらないのだから、安ければ安いほどいいに決まってます。 リピします。
- info10
- リピート購入です。 洗い上がりがさっぱりしています。妙なツッパリ感もないので,いいです。 普通に購入すると,簡単に購入できる金額ではないでしょうが,このように安く提供してもらえるとありがたいです。
- うまれん8083
- 香りは、ラベンダーっぽくはないですが、洗い上がりが、さっぱりして・・・なんか身体が消毒されたような気持ちになり、とても気持ち良いです。ハワイのホテルに置いてあるので・・・なにか懐かしい香りです。 これからも、ずっと愛用したいです。
すべて見る
お店の情報
7,367
連絡・応対
4.3
配送スピード
4.3
梱包
4.3